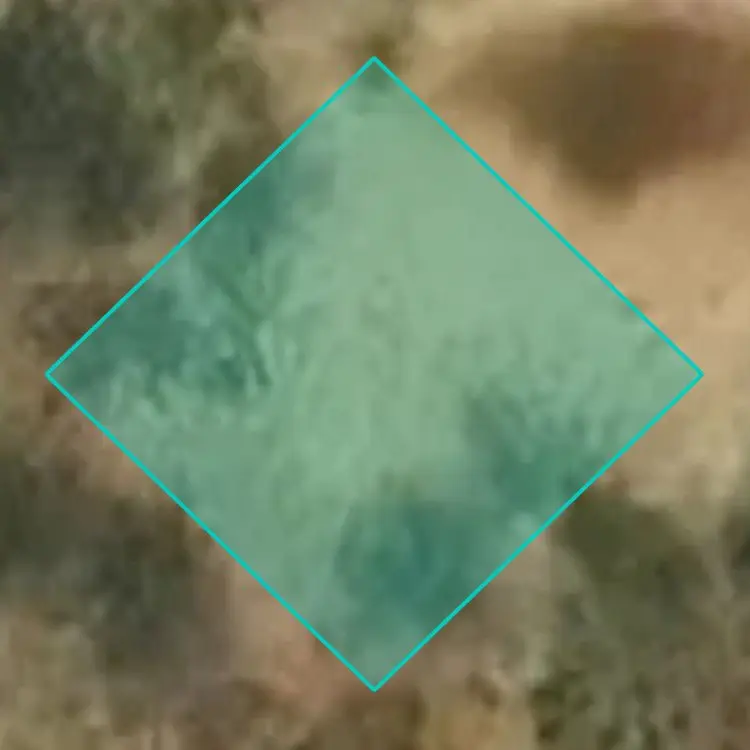

Popular Fishing Spots Near Doesn'T Catch Squat

Lakeside Lake
18.3 mi away • Tucson, Arizona
187
Catches

Silverbell Lake
29.8 mi away • Tucson, Arizona
120
Catches

Patagonia Lake
30 mi away • Santa Cruz County, Arizona
97
Catches

Kennedy Lake
23.4 mi away • Tucson, Arizona
92
Catches

Peña Blanca Lake
41 mi away • Santa Cruz County, Arizona
82
Catches

Sahuarita Lake
13.6 mi away • Sahuarita, Arizona
37
Catches

Parker Lake
37.7 mi away • Cochise County, Arizona
24
Catches

Arivaca Lake
40.3 mi away • Pima County, Arizona
21
Catches